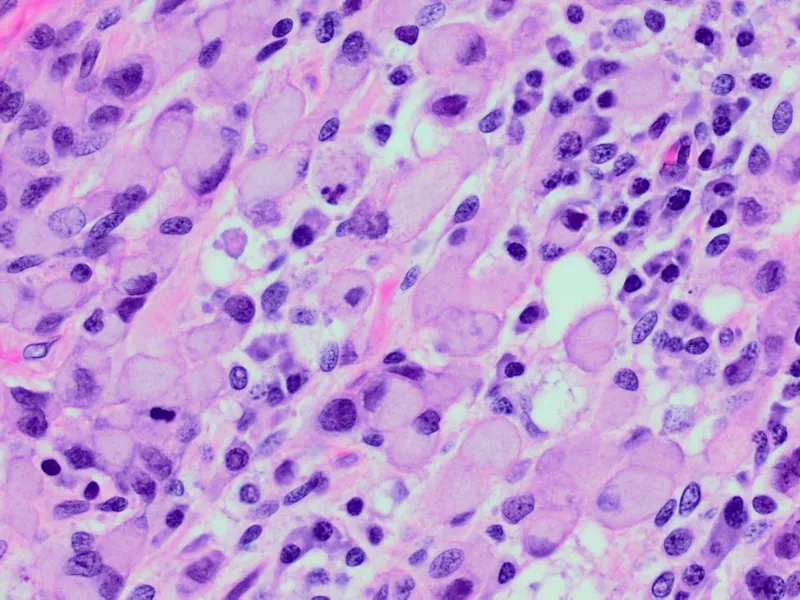
Signet ring cells in gastric adenocarcinoma

GI Polyps Overview - Polyp Parade Primer
Polyp: Abnormal tissue growth protruding from mucous membrane into lumen. Classification:
- Histology (Malignant Potential):
- Non-neoplastic: Low/no malignant risk (hyperplastic, inflammatory, hamartomatous).
- Neoplastic: Premalignant/malignant (adenoma, carcinoma).
- Gross Appearance (Shape):
- Sessile: Broad-based, flat.
- Pedunculated: Stalked.

⭐ Adenomatous polyps are common neoplastic polyps, precursors to colorectal cancer.
Non-Neoplastic Polyps - Benign Bumps
- Hyperplastic: Most common; colonic; serrated/sawtooth crypts on histology; usually no malignant potential.
- Inflammatory (Pseudopolyps): Result from mucosal damage/repair (e.g., IBD); inflamed granulation tissue; no malignant potential.
- Hamartomatous: Disorganized, mature tissue.
- Peutz-Jeghers Polyps: Arborizing smooth muscle core. Syndrome (AD): mucocutaneous pigmentation, ↑ risk of GI & non-GI cancers (pancreas, breast, lung, ovary, testis). 📌 PJS: Pigmentation, Jejunum, Sex-cord tumors.
⭐ Peutz-Jeghers syndrome carries a notable lifetime risk for various cancers, including pancreatic and breast.
- Juvenile Polyposis: Cystically dilated glands, inflamed stroma. Syndrome (AD): ↑ colorectal cancer risk if multiple polyps (> extbf{5}).

- Peutz-Jeghers Polyps: Arborizing smooth muscle core. Syndrome (AD): mucocutaneous pigmentation, ↑ risk of GI & non-GI cancers (pancreas, breast, lung, ovary, testis). 📌 PJS: Pigmentation, Jejunum, Sex-cord tumors.
Adenomatous Polyps - The Risky Raisins
- Neoplastic polyps; precursors to colorectal cancer (CRC).
- Types:
- Tubular: Most common (~75%), pedunculated, lowest risk.
- Villous: Sessile, frond-like; highest malignant risk. 📌 Villainous Villous!
- Tubulovillous: Mix, intermediate risk.
- All show epithelial dysplasia (low/high grade).
- Malignancy Risk Factors: Size (> 2cm), villous architecture, high-grade dysplasia.
- Adenoma-Carcinoma Sequence:

⭐ Villous adenomas, though less common than tubular, carry the highest risk of progressing to carcinoma.
Colorectal Carcinoma - The Colon Culprit
- Epidemiology: Common; Risks: age, diet (↓fiber, ↑red meat), IBD (UC > Crohn's), family Hx (FAP, Lynch).
- Molecular Pathways:
- APC/β-catenin (CIN, ~80%): Chromosomal instability.
- MSI (~15%): Defective DNA mismatch repair (dMMR).
| Feature | Left-Sided (Distal) | Right-Sided (Proximal) |
|---|---|---|
| Lesion | Annular, "apple-core" | Polypoid, exophytic |
| Symptoms | Obstruction, ↓stool caliber, hematochezia | Anemia (occult bleed), fatigue, mass |
| Mnemonic 📌 | L: Lumen narrowing | R: Right-sided Bleeds |
- Staging (TNM): T (invasion depth), N (nodes), M (mets: liver, lung).
- Screening: Colonoscopy (age 45-50), FOBT.
⭐ Right-sided colon cancers often present with iron-deficiency anemia; left-sided with altered bowel habits/obstruction.
Other Key GI Neoplasms - Gut's Varied Villains
- Esophageal Ca:
- SCC: Upper 2/3; Risks: Smoking, alcohol.
- Adeno: Lower 1/3; From Barrett's esophagus.
- Stomach Ca (Adeno): Lauren classification.
- Intestinal: Glandular; H. pylori, nitrosamines.
- Diffuse: Signet ring cells; Linitis plastica.
- GISTs: CD117 (c-KIT)+; Interstitial cells of Cajal origin.
- Carcinoids: Neuroendocrine (NETs); Appendix/ileum common; Serotonin.
- MALT Lymphoma: Stomach; Strong H. pylori association.
⭐ Diffuse type gastric cancer (signet ring cells, linitis plastica) often presents at an advanced stage and has a poorer prognosis than intestinal type.
Hereditary GI Cancer Syndromes - Family Fault Lines
- FAP: APC (AD). 100s+ adenomas; CRC ~100% by age 40.
- Gardner: FAP variant (APC). Polyps, osteomas, desmoid tumors.
- Turcot: APC/MMR genes (AD). Polyps + CNS tumors (medulloblastoma/glioblastoma).
- Lynch (HNPCC): MSH2, MLH1 (AD). Early CRC (often proximal), endometrial Ca. 📌 Amsterdam II/Bethesda criteria.
- Peutz-Jeghers: STK11 (AD). Hamartomatous polyps, mucocutaneous pigmentation. ↑GI, breast, pancreas Ca risk.
- Juvenile Polyposis: SMAD4, BMPR1A (AD). Hamartomatous polyps. ↑CRC, gastric Ca risk.

⭐ Lynch syndrome (HNPCC) is the most common cause of inherited colorectal cancer, accounting for 2-4% of all CRCs.
High‑Yield Points - ⚡ Biggest Takeaways
- FAP: APC gene mutation, numerous adenomas, 100% CRC risk untreated; colectomy vital.
- Lynch Syndrome (HNPCC): MMR gene defects; ↑ CRC (right-sided) & endometrial cancer.
- Peutz-Jeghers: STK11/LKB1; hamartomas, pigmentation; ↑ multi-cancer risk.
- Adenoma-carcinoma sequence: APC → KRAS → p53 mutations drive most CRCs.
- Serrated polyps (SSA/P): Malignant potential, linked to BRAF mutations, CIMP pathway.
- Juvenile polyps: Common in children; syndrome form (JPS) has ↑ CRC risk.
Unlock the full lesson and continue reading
Signup to continue reading this lesson and unlimited access questions, flashcards, AI notes, and more